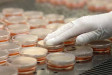

- Запитання про бажану зарплату на співбесіді: Білл Гейтс назвав ідеальну відповідь
- У Швейцарії вирішили, чи прийматиме країна "Євробачення-2025"
- Букерівська премія 2024 оголосила переможця
- Євро різко подешевшав: який курс пропонують банки та обмінники
- Відомий український актор-воїн різко засудив противників мобілізації
- На фронті трагічно загинув відомий харківський музикант
- Серіал "Сварка" отримає продовження: про що буде новий сезон та хто зіграє головні ролі
- Найкращі українські фільми року: оголошено переможців премії "Кіноколо-2024"
- Скандальний Каньє Вест розлучається з Б'янкою Цензорі, – ЗМІ
- Не Tesla і не Toyota: названо найпопулярніший автомобіль в Європі
- Бос Ryanair хоче, щоб аеропорти обмежили продаж алкоголю пасажирам перед рейсами
- Що потрібно, щоб бути щасливим: відмовтеся від цих 7 речей
- Вперше за чотири роки: ще одна країна візьме участь у "Євробаченні-2025"
- Богуслаєв з сином купили 19 елітних апартаментів у Дубаї, - Схеми
- Де дивитися Євробачення 2024 онлайн: список платформ
- Євробачення-2024: Джамала оцінила шанси Alyona Alyona і Jerry Heil у фіналі шоу
- Teresa & Maria: текст і сенс пісні учасниць України на Євробаченні 2024
- "Євробачення-2024": букмекери спрогнозували, хто переможе у першому півфіналі
- Коли і де дивитися Євробачення 2024: дата, список онлайн-платформ
- Археологи виявили мікропластик у стародавніх шарах землі
- Зірковий час для електромобілів: названо найкращий у світі автомобіль за підсумками року
- "Це щасливе число": названо номер виступу України на "Євробаченні-2024"
- Берлінську техно-сцену внесли до списку культурної спадщини ЮНЕСКО
- Маск хоче приховати лайки та репости в соцмережі X
- Серіал "Слово пацана" був знятий спеціально під вибори Путіна - ЗМІ
Медицина
- Саміт на Алясці став "великою аферою" Путіна, - WSJ
- Індія зухвало відмовила Трампу, нагадавши про торгівлю США і РФ
- Трампу імпічмент, Венсу – посаду: Маск продовжує підливати масла у вогонь
- У США закликали видворити Маска з країни після сварки з Трампом, - The Hill
- Ключовий союзник Трампа підтримав законопроект про пекельні санкції проти РФ
- Зеленский раскрыл, чего ожидает от нового президента Польши
- Эра Google прошла: на смартфонах Samsung будет новый ИИ по умолчанию вместо Gemini
- Премьер Дании сделала заявление об украинской операции "Паутина"
- Іран постачає зброю Росії через Каспій, Захід не може цьому завадити - CNN
- ЗМІ дізналися, що НАТО запропонує Києву на літньому саміті у Вільнюсі
- Вперше за два роки: ціни на газ в Європі впали до психологічного мінімуму
- Из-за войны в Украине крупнейший инвестиционный фонд в мире потерял $164 миллиарда - Bloomberg
-
Нет "русскому миру"? Киргизия намерена перевести госучреждения на родной язык
-
Израиль увеличит помощь Украине в гуманитарной и других сферах, - МИД
-
Немецкий производитель готов передать Украине 100 боевых танков, включая Leopard, - СМИ
-
Сингапур помогает России экспортировать нефть. Bloomberg узнал детали
-
РФ продолжает держать свои ракетоносители в Черном море: в ВМС назвали их количество
-
"Как он смеет": США и Израиль резко раскритиковали Лаврова за слова о россиянах и Холокосте
-
Черниговская областная прокуратура подала иски о возвращении в собственность принадлежащих РФ земель...
-
Франция рассматривает передачу Украине своих основных танков Leclerc, - Politico
-
В России бросились к ядерным угрозам накануне "Рамштайна". Джонсон призвал не верить
-
"Все стало сложнее". В Турции оценили возможность переговоров между Украиной и Россией
-
Зеленский не видит с кем говорить в России: не до конца пойму, жив ли Путин
-
Премьер-министр Новой Зеландии подала в отставку
-
В Армении в результате пожара в казарме погибли 15 солдат
 Олена Тополя відверто зізналася, що робила пластику грудей
Олена Тополя відверто зізналася, що робила пластику грудей
 "Увійшов у кураж": блогер розповів про реакцію Єфросиніної на жорсткий жарт на Нацвідборі
"Увійшов у кураж": блогер розповів про реакцію Єфросиніної на жорсткий жарт на Нацвідборі
 Олена Кравець із "Кварталу 95" змінила рід діяльності
Олена Кравець із "Кварталу 95" змінила рід діяльності
 Під час концерту відомого американського репера сталася стрілянина з пораненими
Під час концерту відомого американського репера сталася стрілянина з пораненими
 Голлівудська акторка Віра Фарміга заспівала "Червону руту" і підтримала українців
Голлівудська акторка Віра Фарміга заспівала "Червону руту" і підтримала українців
 Зірка серіалу "Дивні дива" Седі Сінк зніметься у новому фільмі "Людина-павук"
Зірка серіалу "Дивні дива" Седі Сінк зніметься у новому фільмі "Людина-павук"
 Ексвійськова Євгенія Емеральд зробила пластичну операцію
Ексвійськова Євгенія Емеральд зробила пластичну операцію
 Відома американська акторка підтримала Зеленського і назвала розмову в Білому домі ганебною
Відома американська акторка підтримала Зеленського і назвала розмову в Білому домі ганебною
 Потап схуд на 20 кілограмів і здивував своїм перевтіленням
Потап схуд на 20 кілограмів і здивував своїм перевтіленням
 "Придумати своє не може": Каменських в мережі звинуватили у плагіаті відомого хіта
"Придумати своє не може": Каменських в мережі звинуватили у плагіаті відомого хіта
 Викладача Львівського університету імені Франка звільнили після звинувачень у домаганнях
Викладача Львівського університету імені Франка звільнили після звинувачень у домаганнях
 Зала вибухнула оваціями: ведучий "Оскара-2025" пройшовся по фільму "Анора" з акторами з РФ
Зала вибухнула оваціями: ведучий "Оскара-2025" пройшовся по фільму "Анора" з акторами з РФ
 Саміт на Алясці став "великою аферою" Путіна, - WSJ
Саміт на Алясці став "великою аферою" Путіна, - WSJ
 Моді відмовився зупинити імпорт російської нафти, - Bloomberg
Моді відмовився зупинити імпорт російської нафти, - Bloomberg
 Путін "не виключає" зустрічі із Зеленським, але є одне "але", - Politico
Путін "не виключає" зустрічі із Зеленським, але є одне "але", - Politico
 "Дедлайн" Трампа для Кремля може пройти тихо і без наслідків, - AP
"Дедлайн" Трампа для Кремля може пройти тихо і без наслідків, - AP
 Порошенко залишив собі слона і причіп, а всі дохідні активи намагався переписати на дружину, - ЗМІ
Порошенко залишив собі слона і причіп, а всі дохідні активи намагався переписати на дружину, - ЗМІ
 Унікальна спецоперація: СБУ втретє вразила Кримський міст
Унікальна спецоперація: СБУ втретє вразила Кримський міст
 Ключовий союзник Трампа підтримав законопроект про пекельні санкції проти РФ
Ключовий союзник Трампа підтримав законопроект про пекельні санкції проти РФ
 Ігнат про "Павутину": Тривалий час РФ не зможе бити по Україні ракетами
Ігнат про "Павутину": Тривалий час РФ не зможе бити по Україні ракетами
 Переговори у Стамбулі провалились, РФ висунула свої "звичайні" вимоги", - FT
Переговори у Стамбулі провалились, РФ висунула свої "звичайні" вимоги", - FT
 Зеленский раскрыл, чего ожидает от нового президента Польши
Зеленский раскрыл, чего ожидает от нового президента Польши
 Премьер Дании сделала заявление об украинской операции "Паутина"
Премьер Дании сделала заявление об украинской операции "Паутина"
 Зеленский об операции "Паутина": Потери заставят Россию сесть за стол переговоров
Зеленский об операции "Паутина": Потери заставят Россию сесть за стол переговоров
 Збільшення видобутку ОПЕК+ та нові погрози Трампа тиснуть на ціни на нафту
Збільшення видобутку ОПЕК+ та нові погрози Трампа тиснуть на ціни на нафту
 Як рясні дощі вплинуть на врожай картоплі в Україні: відповідь фермера
Як рясні дощі вплинуть на врожай картоплі в Україні: відповідь фермера
 ЕС в мае увеличил импорт "голубого топлива" из РФ, - Reuters
ЕС в мае увеличил импорт "голубого топлива" из РФ, - Reuters
 На главу Центробанка РФ давят из-за проблем в экономике, - Bloomberg
На главу Центробанка РФ давят из-за проблем в экономике, - Bloomberg
 Семья Портнова вложила более $2 миллионов в дубайскую недвижимость, - расследование
Семья Портнова вложила более $2 миллионов в дубайскую недвижимость, - расследование
 Миллиардные потери для бюджета: украинский лом идет в Турцию через Польшу
Миллиардные потери для бюджета: украинский лом идет в Турцию через Польшу
 Економіст пояснив, чому масова мобілізація в Україні неможлива
Економіст пояснив, чому масова мобілізація в Україні неможлива
 На нас чекає новий сплеск цін на продукти: експерт зробив сумний прогноз
На нас чекає новий сплеск цін на продукти: експерт зробив сумний прогноз
 Українці за півроку придбали понад 12 тисяч електромобілів: що зараз купують
Українці за півроку придбали понад 12 тисяч електромобілів: що зараз купують
 Під час війни Україна збільшила експорт в чотири рази: що та кому продаємо
Під час війни Україна збільшила експорт в чотири рази: що та кому продаємо
 Голова МАГАТЕ приїхав на Запорізьку АЕС
Голова МАГАТЕ приїхав на Запорізьку АЕС
 На польскому кордоні заблоковано рух вантажівок з України: що відбувається
На польскому кордоні заблоковано рух вантажівок з України: що відбувається
 Уряд РФ готується до падіння експорту нафти до Індії на 30% та дефіциту бюджету
Уряд РФ готується до падіння експорту нафти до Індії на 30% та дефіциту бюджету
 Моді відмовився зупинити імпорт російської нафти, - Bloomberg
Моді відмовився зупинити імпорт російської нафти, - Bloomberg
 Троянди та гортензії будуть чудово цвісти усе літо: чим підживити кущі
Троянди та гортензії будуть чудово цвісти усе літо: чим підживити кущі
 Куркума і чорний перець творять чудеса: вчені пояснили, чому їх треба приймати разом
Куркума і чорний перець творять чудеса: вчені пояснили, чому їх треба приймати разом
 Позбавляє свободи: туристи відзначили неприємну тенденцію в популярних містах
Позбавляє свободи: туристи відзначили неприємну тенденцію в популярних містах
 Припинення вогню на 30 днів: позиція Путіна ставить Трампа у складне становище, - WSJ
Припинення вогню на 30 днів: позиція Путіна ставить Трампа у складне становище, - WSJ
 Ніхто так не робить: туристи розповіли про свої незвичайні ритуали під час відпочинку
Ніхто так не робить: туристи розповіли про свої незвичайні ритуали під час відпочинку
 Туристка закликала забути про один тип ручної поклажі, якщо не хочеться проблем із Ryanair і Wizz Air
Туристка закликала забути про один тип ручної поклажі, якщо не хочеться проблем із Ryanair і Wizz Air
 Командувача ОК "Північ" Красильникова звільнили з посади, - ЗМІ
Командувача ОК "Північ" Красильникова звільнили з посади, - ЗМІ
 Що зробить Трамп, якщо Путін відмовиться від перемир'я: аналіз The Telegraph
Що зробить Трамп, якщо Путін відмовиться від перемир'я: аналіз The Telegraph
 Названо чотири міста в Європі, які мають дуже італійський вигляд, але дешевші та без натовпів
Названо чотири міста в Європі, які мають дуже італійський вигляд, але дешевші та без натовпів
 Шанувальник McDonald's відвідав ресторани у 55 країнах світу і назвав свій улюблений заклад
Шанувальник McDonald's відвідав ресторани у 55 країнах світу і назвав свій улюблений заклад
 З боксу у футбол: Ф'юрі оголосив, що стане тренером збірної Англії
З боксу у футбол: Ф'юрі оголосив, що стане тренером збірної Англії
 Голкіпер, який грав з Кріштіану Роналду, розповів, яким насправді був футболіст поза грою
Голкіпер, який грав з Кріштіану Роналду, розповів, яким насправді був футболіст поза грою
 Визначилися всі чвертьфіналісти Ліги чемпіонів
Визначилися всі чвертьфіналісти Ліги чемпіонів
 Ексголкіпер збірної України оголосив про завершення кар'єри
Ексголкіпер збірної України оголосив про завершення кар'єри
 Лунін може покинути "Реал" вже цього літа, - ЗМІ
Лунін може покинути "Реал" вже цього літа, - ЗМІ
 Ліга чемпіонів УЄФА: визначено всі команди, які зіграють в 1/8 фіналу
Ліга чемпіонів УЄФА: визначено всі команди, які зіграють в 1/8 фіналу
 Іспанський топ-клуб готовий викласти 20 млн євро за лідера збірної України з футболу
Іспанський топ-клуб готовий викласти 20 млн євро за лідера збірної України з футболу
 Відомий боксер розкрив причину, чому Берінчик програв американцю Девісу
Відомий боксер розкрив причину, чому Берінчик програв американцю Девісу
 Молодий ірландський боксер помер через травму, отриману в титульному бою
Молодий ірландський боксер помер через травму, отриману в титульному бою
 Белью назвав боксера, який має сильніший удар, ніж Усик
Белью назвав боксера, який має сильніший удар, ніж Усик
 Олександр Усик зізнався, що йому не подобався бокс
Олександр Усик зізнався, що йому не подобався бокс
 Володимир Кличко може повернутися на ринг: його промоутер назвав єдину умову
Володимир Кличко може повернутися на ринг: його промоутер назвав єдину умову
 Эра Google прошла: на смартфонах Samsung будет новый ИИ по умолчанию вместо Gemini
Эра Google прошла: на смартфонах Samsung будет новый ИИ по умолчанию вместо Gemini
 Названа самая популярная версия Windows в 2025 году – что выбирают украинцы
Названа самая популярная версия Windows в 2025 году – что выбирают украинцы
 Глава OpenAI потролив Маска у відповідь на пропозицію купити їх за $97 мільярдів
Глава OpenAI потролив Маска у відповідь на пропозицію купити їх за $97 мільярдів
 Apple не поспішає: названо терміни випуску першого гнучкого iPhone
Apple не поспішає: названо терміни випуску першого гнучкого iPhone
 Google перекриває заробіток розробникам додатків з Росії
Google перекриває заробіток розробникам додатків з Росії
 Apple може сильно розчарувати тих, хто чекає на "ультратонкий" iPhone 17 Air
Apple може сильно розчарувати тих, хто чекає на "ультратонкий" iPhone 17 Air
 Новий складаний смартфон від Samsung може бути набагато дешевшим, ніж попередники
Новий складаний смартфон від Samsung може бути набагато дешевшим, ніж попередники
 Названо смартфон із найкращою селфі-камерою на сьогодні
Названо смартфон із найкращою селфі-камерою на сьогодні
 Найбільша у світі амфібія може мати 9 окремих видів, - дослідження
Найбільша у світі амфібія може мати 9 окремих видів, - дослідження
 Які iPhone найбільше подобаються людям – лідером став 4-річний апарат
Які iPhone найбільше подобаються людям – лідером став 4-річний апарат
 Складено рейтинг найкращих відеокарт Nvidia для купівлі восени 2024 року
Складено рейтинг найкращих відеокарт Nvidia для купівлі восени 2024 року
 Відомий Apple-інсайдер уточнив дату виходу нових MacBook і iPad
Відомий Apple-інсайдер уточнив дату виходу нових MacBook і iPad
 Перша повітряна пошта: біолог розповів, як люди відправляли повідомлення за допомогою птахів
Перша повітряна пошта: біолог розповів, як люди відправляли повідомлення за допомогою птахів
 Тане у роті: рецепт ідеального бісквітного пирога від ресторанного критика
Тане у роті: рецепт ідеального бісквітного пирога від ресторанного критика
 Експерти розповіли, як правильно зберігати мед
Експерти розповіли, як правильно зберігати мед
 Тануть у роті: шеф-кухар поділилася рецептом запашних булочок, які готуються за 15 хвилин
Тануть у роті: шеф-кухар поділилася рецептом запашних булочок, які готуються за 15 хвилин
 Чому на Марсі "зникає" сонячний вітер: учені пояснили рідкісне явище
Чому на Марсі "зникає" сонячний вітер: учені пояснили рідкісне явище
 Підозрювали роками: королева Єлизавета II не знала про радянського шпигуна у своєму палаці
Підозрювали роками: королева Єлизавета II не знала про радянського шпигуна у своєму палаці
 Спатифілум буде здоровим і зацвіте, якщо додати один натуральний продукт
Спатифілум буде здоровим і зацвіте, якщо додати один натуральний продукт
 NASA створить космічний радіатор розміром як футбольне поле: навіщо він потрібен
NASA створить космічний радіатор розміром як футбольне поле: навіщо він потрібен
 Учені назвали підробкою стародавнього морського монстра, витягнутого з марокканської шахти
Учені назвали підробкою стародавнього морського монстра, витягнутого з марокканської шахти
 Фізик розв'язав відомий часовий парадокс, що унеможливлює подорожі в часі
Фізик розв'язав відомий часовий парадокс, що унеможливлює подорожі в часі
 Моторошний затишок: місто-привид у пустелі Намібії надзвичайно приваблює туристів
Моторошний затишок: місто-привид у пустелі Намібії надзвичайно приваблює туристів
 Панеттоне на Різдво: італійський пекар розповів, як їсти цю випічку та на що звернути увагу
Панеттоне на Різдво: італійський пекар розповів, як їсти цю випічку та на що звернути увагу
 Що буде з організмом, якщо відмовитися від м'яса: чотири вагомі причини спробувати
Що буде з організмом, якщо відмовитися від м'яса: чотири вагомі причини спробувати
 Дієтолог назвала 6 "поганих" продуктів, які слід їсти для здоров'я серця
Дієтолог назвала 6 "поганих" продуктів, які слід їсти для здоров'я серця
 Диетологи назвали четыре продукта, которыми можно успокоить нервы
Диетологи назвали четыре продукта, которыми можно успокоить нервы
 Викидання мотлоху з життя для душевного спокою: психолог розповів, з чого почати
Викидання мотлоху з життя для душевного спокою: психолог розповів, з чого почати
 Як схуднути після 50: тренер порадив 8 простих вправ
Як схуднути після 50: тренер порадив 8 простих вправ
 10 дивацтв у поведінці дітей, які є ознакою геніальності
10 дивацтв у поведінці дітей, які є ознакою геніальності
 Чому корисно їсти яйця в літньому віці: дієтолог назвав їхній головний секрет
Чому корисно їсти яйця в літньому віці: дієтолог назвав їхній головний секрет
 Надає ситність та поживні властивості: дієтолог назвала овоч №1 для схуднення
Надає ситність та поживні властивості: дієтолог назвала овоч №1 для схуднення
 Що корисно для нігтів: дієтологи назвали найкращі продукти
Що корисно для нігтів: дієтологи назвали найкращі продукти
 Тисячі випадків захворювання: ВООЗ зафіксувала смертельний вірус у ще трьох країнах
Тисячі випадків захворювання: ВООЗ зафіксувала смертельний вірус у ще трьох країнах
 Учені розкрили незвичайний зв'язок між довжиною пальців і тягою до алкоголю
Учені розкрили незвичайний зв'язок між довжиною пальців і тягою до алкоголю
 І смачно, і корисно: дієтологиня назвала найкращу альтернативу сиру
І смачно, і корисно: дієтологиня назвала найкращу альтернативу сиру
 Поліція знайшла пістолет під час обшуку квартири у справі про вбивство Фаріон
Поліція знайшла пістолет під час обшуку квартири у справі про вбивство Фаріон
 Підозрюваний у вбивстві Фаріон відмовився давати свідчення
Підозрюваний у вбивстві Фаріон відмовився давати свідчення
 Вбивство Фаріон: ймовірному нападнику повідомили про підозру
Вбивство Фаріон: ймовірному нападнику повідомили про підозру
 Підозрюваного у вбивсті Фаріон затримали, - Зеленський
Підозрюваного у вбивсті Фаріон затримали, - Зеленський
 В Україні повідомили про підозру діючому міністру агрополітики
В Україні повідомили про підозру діючому міністру агрополітики
 Пашинський вийшов на свободу під заставу
Пашинський вийшов на свободу під заставу
 Суд продовжив строк досудового розслідування у справі Коломойського
Суд продовжив строк досудового розслідування у справі Коломойського
 Повітряні сили розповіли деталі про нічну атаку окупантів
Повітряні сили розповіли деталі про нічну атаку окупантів
 Россия нарастила поставки дизеля перед эмбарго ЕС, - Reuters
Россия нарастила поставки дизеля перед эмбарго ЕС, - Reuters
 В Иране готовятся казнить бывшего замминистра обороны
В Иране готовятся казнить бывшего замминистра обороны
 МВД объявило в розыск российского предпринимателя Бориса Зимина
МВД объявило в розыск российского предпринимателя Бориса Зимина
 В Крыму журналистку Данилович приговорили к семи годам колонии
В Крыму журналистку Данилович приговорили к семи годам колонии
- Путін "не виключає" зустрічі із Зеленським, але є одне "але", - Politico
- Збільшення видобутку ОПЕК+ та нові погрози Трампа тиснуть на ціни на нафту
- На лінії фронту в Україні зона ураження стає дедалі глибшою: в The Economist назвали причини
- У російському Брянську пролунали потужні вибухи в районі аеропорту
- Росія планує у 2026 році захопити дві області та відрізати Україну від Чорного моря, - ОП
- Низка поїздів спізнюється через наслідки атаки на Київ
- Під час нічного удару росіян у Києві загинули рятувальники
- Порошенко залишив собі слона і причіп, а всі дохідні активи намагався переписати на дружину, - ЗМІ
- В Україні з'явиться військовий омбудсмен: Рада зробила перший крок
- Унікальна спецоперація: СБУ втретє вразила Кримський міст
- Росіяни зберігають можливості для масованих авіаударів, але тепер вони обмежені, - експерт
- Генштаб відзвітував про знищення 12 російських літаків
- Ігнат про "Павутину": Тривалий час РФ не зможе бити по Україні ракетами
- Переговори у Стамбулі провалились, РФ висунула свої "звичайні" вимоги", - FT
-
Черниговская областная прокуратура подала иски о возвращении в собственность принадлежащих РФ земель...
-
Зеленский не видит с кем говорить в России: не до конца пойму, жив ли Путин
- У Путина пригрозили "затягиванием" войны и бедами в случае поставок танков Украине
- В Беларусь прибыли еще два эшелона с техникой и солдатами РФ, - Гаюн
- Пригожин хочет захватить соляные шахты в Соледаре: в Минобороны объяснили, зачем
- При участии Путина. Кремль начал подготовку к президентским выборам, - СМИ
- В России начали чаще возвращать на войну недолеченных оккупантов, - СМИ
- Россия вывела в Черное море на боевое дежурство носитель "Калибров", - Гуменюк
- Путину, может быть, самому придется командовать своими войсками, - посол
- В Москве очередной пожар на складах: сотни людей пришлось эакуировать
- В России произошло два ЧП с самолетами
Популярное